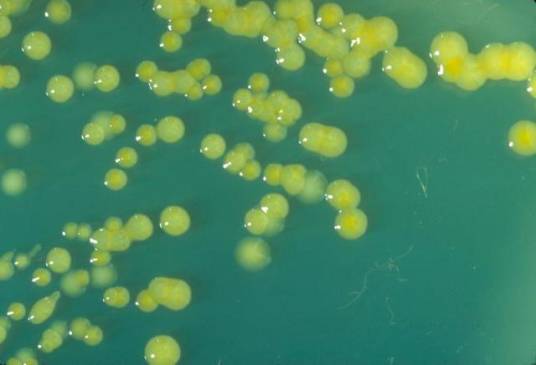
阪崎肠杆菌

阪崎肠杆菌
的有关信息介绍如下:
阪崎肠杆菌(又称阪崎氏肠杆菌)是肠杆菌科的一种,1980年由黄色阴沟肠杆菌更名为阪崎肠杆菌。阪崎肠杆菌能引起严重的新生儿脑膜炎、小肠结肠炎和菌血症,死亡率高达50% 以上。微生物学家尚不清楚阪崎肠杆菌的污染来源,但许多病例报告表明婴儿配方粉是发现的主要感染渠道。
想要了解更多“阪崎肠杆菌”的信息,请点击:阪崎肠杆菌百科
阪崎肠杆菌(又称阪崎氏肠杆菌)是肠杆菌科的一种,1980年由黄色阴沟肠杆菌更名为阪崎肠杆菌。阪崎肠杆菌能引起严重的新生儿脑膜炎、小肠结肠炎和菌血症,死亡率高达50% 以上。微生物学家尚不清楚阪崎肠杆菌的污染来源,但许多病例报告表明婴儿配方粉是发现的主要感染渠道。
想要了解更多“阪崎肠杆菌”的信息,请点击:阪崎肠杆菌百科